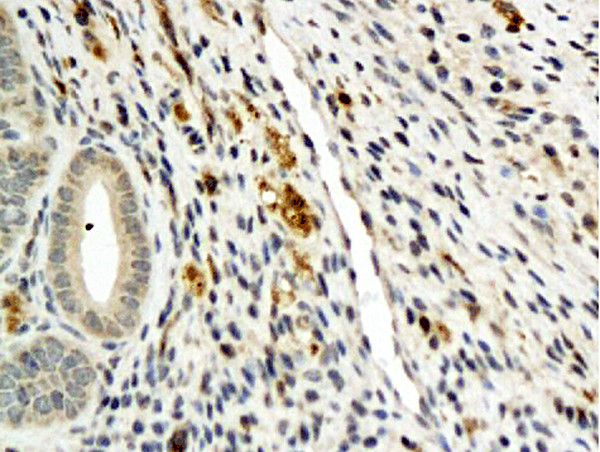
Angiopoietin 4 Antibody in Immunohistochemistry (Paraffin) (IHC (P))

Search
Bioss
Angiopoietin 4 Polyclonal Antibody
{{$productOrderCtrl.translations['antibody.pdp.commerceCard.promotion.promotions']}}
{{$productOrderCtrl.translations['antibody.pdp.commerceCard.promotion.viewpromo']}}
{{$productOrderCtrl.translations['antibody.pdp.commerceCard.promotion.promocode']}}: {{promo.promoCode}} {{promo.promoTitle}} {{promo.promoDescription}}. {{$productOrderCtrl.translations['antibody.pdp.commerceCard.promotion.learnmore']}}
产品信息
BS-1087R
种属反应
宿主/亚型
分类
类型
抗原
偶联物
形式
浓度
规格
纯化类型
保存液
内含物
保存条件
运输条件
靶标信息
Angiopoietin-1 (Ang-1) is a secreted ligand for Tie-2, a cell surface receptor tyrosine kinase expressed in endothelial and hemopoietic cells. Ang-1 is an angiogenic factor that mediates blood vessel maturation and may be involved in endothelial development. A related protein, angiopoietin-2 (Ang-2), is a naturally occurring antagonist of Ang-1 activation of Tie-2. In adult tissue, Ang-2 expression is restricted to sites of vascular remodeling. Ang-3 and Ang-4 represent the mouse and human counterparts of the same gene locus. The structural divergence of Ang-3 and Ang-4 cause their divergent functions. Ang-3 and Ang-4 have very different distributions in their respective species, and Ang-3 appears to act as an antagonist while Ang-4 appears to function as an agonist. Ang-3 and Ang-4 share all the main structural characteristics of Ang-1 and Ang-2 and are homologous throughout the signal peptide, N-terminal region, coiled-coil segment and Fibrinogen-like domain.
仅用于科研。不用于诊断过程。未经明确授权不得转售。
篇参考文献 (0)
生物信息学
蛋白别名: AGP4; ANG-3; ANG-4; angiopoietin 3; Angiopoietin-3; Angiopoietin-4; Angiopoietin3; Angiopoietin4; unnamed protein product
基因别名: Agpt4; ANG3; ANG4; ANGPT4
UniProt ID: (Human) Q9Y264, (Mouse) Q9WVH6
Entrez Gene ID: (Human) 51378, (Mouse) 11602, (Rat) 296269